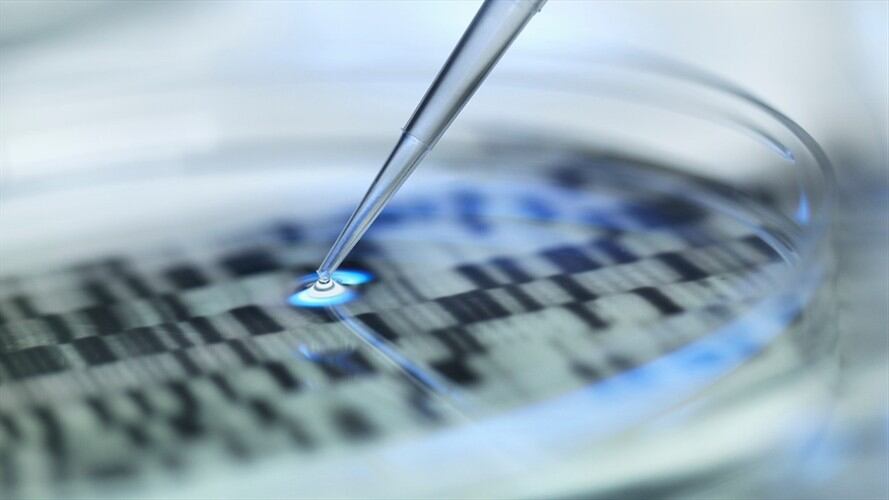
Se pudo confirmar que la causa de la muerte del polémico abogado Jaime Agámez fue un infarto. Foto: Getty Images

Se dan a conocer los resultados de la exhumación del abogado Jaime Agámez
Hace unos meses, el fiscal Néstor Humberto Martínez ordenó esta exhumación.

Se pudo confirmar que la causa de la muerte del polémico abogado Jaime Agámez fue un infarto. Foto: Getty Images(Thot)
La W conoció los resultados de la exhumación hecha al cuerpo del polémico abogado Jaime Agámez, señalado de ser uno de los cerebros del desfalco al magisterio de Córdoba.
(Lea también: Entregué $4.000 millones a Alejandro Lyons: Heliodoro Agámez)
Después de que la Fiscalía le pidiera a Medicina Legal revisar las causas de la muerte del jurista, pues había fuertes rumores sobre un posible envenenamiento, se pudo confirmar que la causa de la muerte fue un infarto.
La solicitud del ente acusador se dio después de que La W revelara los resultados de la exhumación hecha a José Miguel Chica, exsecretario de Educación de Córdoba, y se conociera que este habría muerto envenenado y no por un ataque cardíaco como se dijo al principio.
Agámez murió el 5 de junio del año 2016, días después de prender el ventilador y señalar a varias de las personas que supuestamente participaron del desfalco a la salud de los maestros.
Según fuentes de la Fiscalía, el abogado sería testigo en contra del senador Armando Benedetti.







